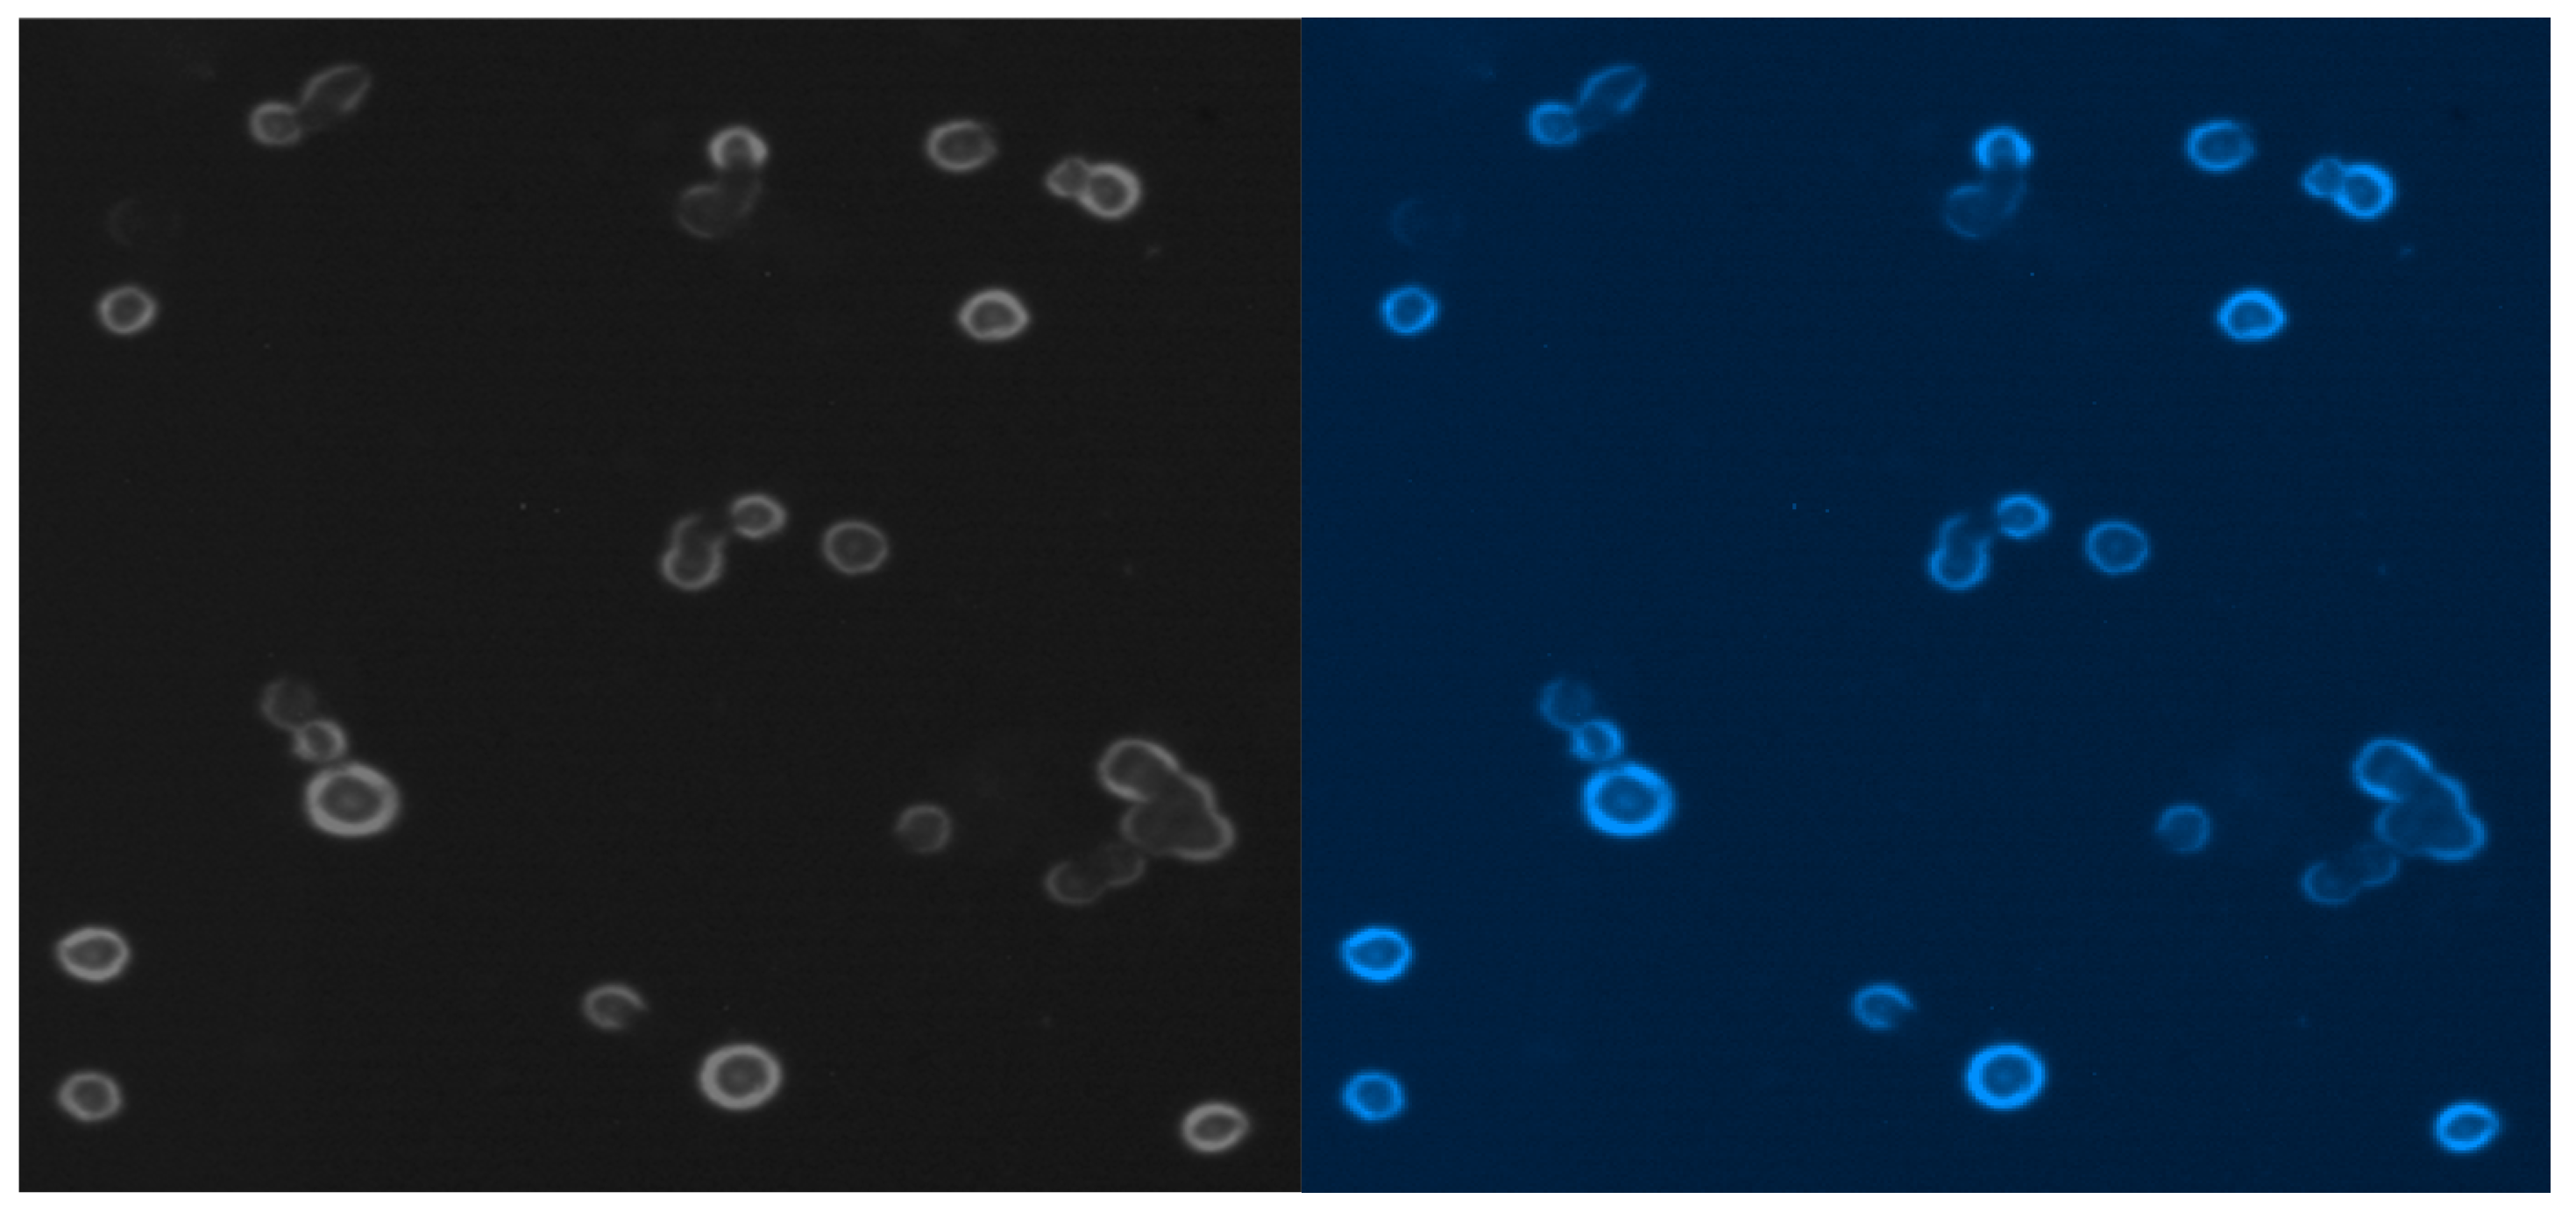
Ijms 25 03009 g009 Ijms 25 03009 g009

Utility of 1.5 Tesla MRI Scanner in the Management of Small Sample Sizes Driven from 3D Breast Cell Culture
Abstract
1. Introduction
2. Results
2.1. Three-Dimensional MCF-7 Cells
2.2. Cellular MRI
3. Discussion
4. Materials and Methods
4.1. Cells
4.2. MRI Equipment
4.3. Growth of Tumor Cells
4.4. Experimental Conditions of MRI and GAG Measurements
4.5. MRI and Relaxation Times
4.6. A Practical Approach to Signal Analysis and Method Validation
| function [f,r2]=timeT1 |
| %vector of TR times for which image acquisitions were made. |
| tr=[500, 700, 1000, 1500, 2000, 3000, 5000, 10000, 15000]’; |
| % signal intensity vector after normalization different for each image pixel (example data for |
| % T1 = 2250ms) |
| is_t1= [ 0.1993 0.2674 0.3588 0.4866 0.5889 0.7364 0.8916 0.9883 0.9987]’; |
| % approximation function lan=’a-b*exp(-(c*x)/1000)’; |
| % approximation of measurement points using the "fit" function |
| %f- contains the values of coefficients a,b,c, |
| %r2 – contains, among others: value of the curve fitting coefficient to the |
| %measurement values R^2 |
| [f,r2]=fit(tr,is_t1,lan); |
| %calculation of T1 time for 63% of values. max. The expression (1-exp(-1))=0.6321 |
| x=1-exp(-1); |
| T1=double(-(1000*log((f.a - x)/f.b))/f.c) |
| plot(tr,is_t1,’*’); hold on; |
| plot(f); |
| title(strcat(’T1=’,num2str(double(T1),4),’ms, R^2 =’,num2str(r2.rsquare))); |
| xlabel(’TR [ms]’); ylabel(’IS’);grid on, grid minor |
| end |
4.7. Subcellular Localization
4.8. Multicolor Staining for the Epifluorescence Microscopy
4.9. Statistical Analysis
5. Conclusions
Author Contributions
Funding
Institutional Review Board Statement
Informed Consent Statement
Data Availability Statement
Conflicts of Interest
References
- Karamanos, N.K.; Tzanakakis, G.N. Glycosaminoglycans: From “cellular glue” to novel therapeutical agents. Curr. Opin. Pharmacol. 2012, 12, 220–222. [Google Scholar] [CrossRef][Green Version]
- Gomez-Florit, M.; Pardo, A.; Domingues, R.M.A.; Graça, A.L.; Babo, P.S.; Reis, R.L.; Gomes, M.E. Natural-Based Hydrogels for Tissue Engineering Applications. Molecules 2020, 25, 5858. [Google Scholar] [CrossRef]
- Theocharis, A.D.; Skandalis, S.S.; Gialeli, C.; Karamanos, N.K. Extracellular matrix structure. Adv. Drug Deliv. Rev. 2016, 97, 4–27. [Google Scholar] [CrossRef]
- Donahue, K.M.; Weisskoff, R.M.; Burstein, D. Water diffusion and exchange as they influence contrast enhancement. J. Magn. Reson. Imaging 1997, 7, 102–110. [Google Scholar] [CrossRef]
- Donahue, K.M.; Burstein, D.; Manning, W.J.; Gray, M.L. Studies of Gd-DTPA relaxivity and proton exchange rates in tissue. Magn. Reson. Med. 1994, 32, 66–76. [Google Scholar] [CrossRef] [PubMed]
- Wiegers, C.B.; Welch, M.J.; Sharp, T.L.; Brown, J.J.; Perman, W.H.; Sun, Y.; Motekaitis, R.J.; Martell, A.E. Evaluation of two new gadolinium chelates as contrast agents for MRI. Magn. Reason. Imaging 1992, 10, 903–911. [Google Scholar] [CrossRef]
- Chabanova, E.; Larsen, L.; Løgager, V.B.; Møller, J.M.; Thomsen, H.S. Anvendelse af MR-skanning [Use of magnetic resonance imaging]. Ugeskr. Laeger 2014, 176, 50–54. [Google Scholar] [PubMed]
- Vinogradov, E. Imaging molecules. J. Magn. Reson. 2019, 306, 145–149. [Google Scholar] [CrossRef] [PubMed]
- Anders, M.; Hansen, R.; Ding, R.X.; Rauen, K.A.; Bissell, M.J.; Korn, W.M. Disruption of 3D tissue integrity facilitates adenovirus infection by deregulating the coxsackievirus and adenovirus receptor. Proc. Natl. Acad. Sci. USA 2003, 100, 1943–1948. [Google Scholar] [CrossRef] [PubMed]
- Gillies, R.J.; Raghunand, N.; Karczmar, G.S.; Bhujwalla, Z.M. MRI of the tumor microenvironment. J. Magn. Reson. Imaging 2002, 16, 430–450, Erratum in J. Magn. Reason. Imaging 2002, 16, 751. [Google Scholar] [CrossRef] [PubMed]
- Slamon, D.J.; Clark, G.M.; Wong, S.G.; Levin, W.J.; Ullrich, A.; McGuire, W.L. Human breast cancer: Correlation of relapse and survival with amplification of the HER-2/neu oncogene. Science 1987, 235, 177–182. [Google Scholar] [CrossRef] [PubMed]
- Brandl, M.; Tonn, J.C.; Kotitschke, K.; Goldbrunner, R.; Kerkau, S.; Haase, A. Quantitative NMR microscopy of multicellular tumor spheroids and confrontation cultures. Magn. Reson. Med. 1995, 34, 596–603. [Google Scholar] [CrossRef] [PubMed]
- Fantazzini, P.; Garavaglia, C.; Gomez, S.; Toffanin, R.; Vittur, F. Chondrocyte-alginate bioconstructs: A nuclear magnetic resonance relaxation study. J. Biomed. Mater. Res. A 2007, 83, 345–353. [Google Scholar] [CrossRef] [PubMed]
- Le Moyec, L.; Pellen, P.; Merdrignac-Le Noan, G.; Le Lan, J.; Lancien, G.; Chenal, C.; de Certaines, J.D. Proton NMR relaxation times of experimental Lewis lung carcinoma after irradiation. Radiother. Oncol. 1988, 3, 1–8. [Google Scholar] [CrossRef] [PubMed]
- Chenevert, T.L.; McKeever, P.E.; Ross, B.D. Proton NMR relaxation times of experimental Lewis lung carcinoma after irradiation. Clin. Cancer Res. 1997, 3, 1457–1466. [Google Scholar] [PubMed]
- Duvvuri, U.; Poptani, H.; Feldman, M.; Nadal-Desbarats, L.; Gee, M.S.; Lee, W.M.; Reddy, R.; Leigh, J.S.; Glickson, J.D. Quantitative T1rho magnetic resonance imaging of RIF-1 tumors in vivo: Detection of early response to cyclophosphamide therapy. Cancer Res. 2001, 61, 7747–7753. [Google Scholar]
- Poptani, H.; Bansal, N.; Graham, R.A.; Mancuso, A.; Nelson, D.S.; Glickson, J.D. Detecting early response to cyclophosphamide treatment of RIF-1 tumors using selective multiple quantum spectroscopy (SelMQC) and dynamic contrast enhanced imaging. NMR Biomed. 2003, 16, 102–111. [Google Scholar] [CrossRef]
- Jakobsen, I.; Kaalhus, O.; Lyng, H.; Rofstad, E.K. Detection of necrosis in human tumour xenografts by proton magnetic resonance imaging. British journal of cancer. Br. J. Cancer 1995, 71, 456–461. [Google Scholar] [CrossRef]
- Liu, H.; Gao, H.; Jia, F. The Value of Convolutional Neural Network-Based Magnetic Resonance Imaging Image Segmentation Algorithm to Guide Targeted Controlled Release of Doxorubicin Nanopreparation. Contrast Media Mol. Imaging 2021, 2021, 9032017. [Google Scholar] [PubMed]
- Aebisher, D.; Truszkiewicz, A.; Osuchowski, M.; Wojtas, Ł.; Dynarowicz, K.; Bartusik-Aebisher, D. Zastosowanie sieci neuronowej do optymalizacji czasu analizy obrazów MR na podstawie krzywych czasów relaksacji T1 i T2 wycinka guza prostaty. Inżynier Fiz. Med. 2023, 12, 241–246. [Google Scholar]
- Palhares, L.C.G.F.; London, J.A.; Kozlowski, A.M.; Esposito, E.; Chavante, S.F.; Ni, M.; Yates, E.A. Chemical Modification of Glycosaminoglycan Polysaccharides. Molecules 2021, 26, 5211. [Google Scholar] [CrossRef] [PubMed]
- Emerman, J.T.; Jones, N.; Fiedler, E.E. Glycosaminoglycan accumulation by normal and malignant human mammary epithelial cells in primary culture. Biochem. Cell Biol. 1988, 66, 309–318. [Google Scholar] [CrossRef] [PubMed]
- Robinson, D.E.; Buttle, D.J.; Short, R.D.; McArthur, S.L.; Steele, D.A.; Whittle, J.D. Glycosaminoglycan (GAG) binding surfaces for characterizing GAG-protein interactions. Biomaterials 2012, 33, 1007–1016. [Google Scholar] [CrossRef] [PubMed]
- Hileman, R.E.; Fromm, J.R.; Weiler, J.M.; Linhardt, R.J. Glycosaminoglycan-protein interactions: Definition of consensus sites in glycosaminoglycan binding proteins. Bioessays 1998, 20, 156–167. [Google Scholar] [CrossRef]
- Baker, B.; Chen, C. Deconstructing the third dimension—How 3D culture microenvironments alter cellular cues. J. Cell Sci. 2012, 125, 3015–3024. [Google Scholar] [CrossRef] [PubMed]
- Hickman, J.A.; Graeser, R.; de Hoogt, R.; Vidic, S.; Brito, C.; Gutekunst, M.; van der Kuip, H. Three-dimensional models of cancer for pharmacology and cancer cell biology: Capturing tumor complexity in vitro/ex vivo. Biotechnol. J. 2014, 9, 1115–1128. [Google Scholar] [CrossRef] [PubMed]
- Griffith, L.G.; Swartz, M.A. Capturing complex 3D tissue physiology in vitro. Nat. Rev. Mol. Cell Biol. 2006, 7, 211–224. [Google Scholar] [CrossRef] [PubMed]
- Lee, J.; Cuddihy, M.J.; Kotov, N.A. Three-dimensional cell culture matrices: State of the art. Tissue Eng. Part B Rev. 2008, 14, 61–86. [Google Scholar] [CrossRef]
- Kilian, K.A.; Bugarija, B.; Lahn, B.T.; Mrksich, M. Geometric cues for directing the differentiation of mesenchymal stem cells. Proc. Natl. Acad. Sci. USA 2010, 107, 4872–4877. [Google Scholar] [CrossRef]
- Ghosh, S.; Spagnoli, G.C.; Martin, I.; Ploegert, S.; Demougin, P.; Heberer, M.; Reschner, A. Three-dimensional culture of melanoma cells profoundly affects gene expression profile: A high density oligonucleotide array study. J. Cell Physiol. 2005, 204, 522–531. [Google Scholar] [CrossRef]
- GWeiswald, L.; Bellet, D.; Dangles-Marie, V. Spherical cancer models in tumor biology. Neoplasia 2015, 17, 1–15. [Google Scholar] [CrossRef] [PubMed]
- Ravi, M.; Paramesh, V.; Kaviya, S.R.; Anuradha, E.; Solomon, F.D. 3D cell culture systems: Advantages and applications. J. Cell Physiol. 2015, 230, 16–26. [Google Scholar] [CrossRef] [PubMed]
- Habanjar, O.; Diab-Assaf, M.; Caldefie-Chezet, F.; Delort, L. 3D Cell Culture Systems: Tumor Application, Advantages, and Disadvantages. Int. J. Mol. Sci. 2021, 22, 12200. [Google Scholar] [CrossRef] [PubMed]
- Culliton, B.J. HeLa (for Henrietta Lacks). Science 1974, 184, 1268. [Google Scholar] [CrossRef] [PubMed]
- O’Brien, S.J. Cell culture forensics. Proc. Natl. Acad. Sci. USA 2001, 98, 7656–7658. [Google Scholar] [CrossRef] [PubMed]
- Levchenko, S.M.; Qu, J. Biomolecular Component Analysis of Phospholipids Composition in Live HeLa Cells. Biosensors 2018, 8, 123. [Google Scholar] [CrossRef] [PubMed]
- Attene-Ramos, M.S.; Huang, R.; Michael, S.; Witt, K.L.; Richard, A.; Tice, R.R.; Simeonov, A.; Austin, C.P.; Xia, M. Profiling of the Tox21 chemical collection for mitochondrial function to identify compounds that acutely decrease mitochondrial membrane potential. Environ. Health Perspect. 2015, 123, 49–56. [Google Scholar] [CrossRef]
- Kameoka, S.; Babiarz, J.; Kolaja, K.; Chiao, E. A high-throughput screen for teratogens using human pluripotent stem cells. Toxicol. Sci. 2014, 137, 76–90. [Google Scholar] [CrossRef]
- Vickers, A.E.; Fischer, V.O.; Connors, S.U.; Fisher, R.L.; Baldeck, J.P.; Maurer, G.E.; Brendel, K.L. Cyclosporin A metabolism in human liver, kidney, and intestine slices. Comparison to rat and dog slices and human cell lines. Drug Metab. Dispos. 1992, 20, 802–809. [Google Scholar]
- Bigaeva, E.; Puerta Cavanzo, N.; Stribos, E.G.; de Jong, A.J.; Biel, C.; Mutsaers, H.A.; Jensen, M.S.; Nørregaard, R.; Leliveld, A.M.; de Jong, I.J.; et al. Predictive value of precision-cut kidney slices as an ex vivo screening platform for therapeutics in human renal fibrosis. Pharmaceutics 2020, 12, 459. [Google Scholar] [CrossRef]
- Ribeiro, A.J.; Yang, X.; Patel, V.; Madabushi, R.; Strauss, D.G. Liver microphysiological systems for predicting and evaluating drug effects. Clin. Pharmacol. Ther. 2019, 106, 139–147. [Google Scholar] [CrossRef]
- Chen, R.; He, J.; Wang, Y.; Guo, Y.; Zhang, J.; Peng, L.; Wang, D.; Lin, Q.; Zhang, J.; Guo, Z.; et al. Qualitative transcriptional signatures for evaluating the maturity degree of pluripotent stem cell-derived cardiomyocytes. Stem Cell Res. Ther. 2019, 10, 113. [Google Scholar] [CrossRef] [PubMed]
- Langenbach, F.; Naujoks, C.; Smeets, R.; Berr, K.; Depprich, R.; Kübler, N.; Handschel, J. Scaffold-free microtissues: Differences from monolayer cultures and their potential in bone tissue engineering. Clin. Oral Investig. 2013, 17, 9–17. [Google Scholar] [CrossRef] [PubMed]
- Ishihara, M.; Kishimoto, S.; Takikawa, M.; Hattori, H.; Nakamura, S.; Shimizu, M. Biomedical application of low molecular weight heparin/protamine nano/micro particles as cell- and growth factor-carriers and coating matrix. Int. J. Mol. Sci. 2015, 16, 11785–11803. [Google Scholar] [CrossRef] [PubMed]
- Colombo, E.; Cattaneo, M.G. Multicellular 3D Models to Study Tumour-Stroma Interactions. Int. J. Mol. Sci. 2021, 22, 1633. [Google Scholar] [CrossRef] [PubMed]
- Hoarau-Véchot, J.; Rafii, A.; Touboul, C.; Pasquier, J. Halfway between 2D and Animal Models: Are 3D Cultures the Ideal Tool to Study Cancer-Microenvironment Interactions? Int. J. Mol. Sci. 2018, 19, 181. [Google Scholar] [CrossRef] [PubMed]
- Archer, B.J.; Uberruck, T.; Mack, J.J.; Youssef, K.; Jarenwattananon, N.N.; Rall, D.; Wypysek, D.; Wiese, M.; Blumich, B.; Wessling, M.; et al. Noninvasive Quantification of Cell Density in Three-Dimensional Gels by MRI. IEEE Trans. Biomed. Eng. 2019, 66, 821–830. [Google Scholar] [CrossRef] [PubMed]
- Jaganathan, H.; Hugar, D.L.; Ivanisevic, A. Examining MRI contrast in three-dimensional cell culture phantoms with DNA-templated nanoparticle chains. ACS Appl. Mater. Interfaces 2011, 3, 1282–1288. [Google Scholar] [CrossRef]
- Eisenbrand, G.; Pool-Zobel, B.; Baker, V.; Balls, M.; Blaauboer, B.J.; Boobis, A.; Carere, A.; Kevekordes, S.; Lhuguenot, J.C.; Pieters, R.; et al. Methods of in vitro toxicology. Food Chem. Toxicol. 2002, 40, 193–236. [Google Scholar] [CrossRef]
- Barton, D.L.; Brooks, T.M.; Cieslak, A.; Elkins, G.R.; Clark, P.M.; Baydoun, M.; Smith, A.B.; Van Poznak, C.H. Phase II randomized controlled trial of hypnosis versus progressive muscle relaxation for body image after breast or gynecologic cancerBreast Cancer Res. Treat 2019, 178, 357–365. [Google Scholar]
- Huang, X.; Ali, T.S.; Nano, T.; Blick, T.; Tse, B.W.; Sokolowski, K.; Tourell, M.C.; Loyd, T.; Thompson, E.W.; Momot, K.I.; et al. Quantification of breast tissue density: Correlation between single-sided portable NMR and micro-CT measurements. Magn. Reson. Imaging 2019, 62, 111–120. [Google Scholar] [CrossRef] [PubMed]
- Cruceriu, D.; Baldasici, O.; Balacescu, O.; Berindan-Neagoe, I. The dual role of tumor necrosis factor-alpha (TNF-α) in breast cancer: Molecular insights and therapeutic approaches. Cell. Oncol. 2020, 43, 1–18. [Google Scholar] [CrossRef]
- Jang, Y.; Cho, E.Y.; Cho, S.Y. Human Epidermal Growth Factor Receptor 2-positive Mucinous Carcinoma with Signet Ring Cell Differentiation, Which Showed Complete Response after Neoadjuvant Chemotherapy. J. Breast Cancer 2019, 22, 336–340. [Google Scholar] [CrossRef] [PubMed]
- Bartusik, D.; Tomanek, B.; Lattová, E.; Perreault, H.; Fallone, G. Ex vivo assays of CEM cells cultured and treated in the three dimensional cultures. Biomed. Pharmacother. 2010, 64, 390–395. [Google Scholar] [CrossRef]
- Bartusik, D.; Tomanek, B. Application of 19F magnetic resonance to study the efficacy of fluorine labeled drugs in the three-dimensional cultured breast cancer cells. Arch. Biochem. Biophys. 2010, 493, 234–241. [Google Scholar] [CrossRef] [PubMed][Green Version]
- Bober, Z.; Aebisher, D.; Olek, M.; Kawczyk-Krupka, A.; Bartusik-Aebisher, D. Multiple Cell Cultures for MRI Analysis. Int. J. Mol. Sci. 2022, 23, 10109. [Google Scholar] [CrossRef]
- Truszkiewicz, A.; Bartusik-Aebisher, D.; Zalejska-Fiolka, J.; Kawczyk-Krupka, A.; Aebisher, D. Cellular Lactate Spectroscopy Using 1.5 Tesla Clinical Apparatus. Int. J. Mol. Sci. 2022, 23, 11355. [Google Scholar] [CrossRef]
- Lee, J.M.; Mhawech-Fauceglia, P.; Lee, N.; Parsanian, L.C.; Lin, Y.G.; Gayther, S.A.; Lawrenson, K. A three-dimensional microenvironment alters protein expression and chemosensitivity of epithelial ovarian cancer cells in vitro. Lab. Investig. 2013, 93, 528–542. [Google Scholar] [CrossRef]
- Li, S.; Yang, K.; Chen, X.; Zhu, X.; Zhou, H.; Li, P.; Chen, Y.; Jiang, Y.; Li, T.; Qin, X.; et al. Simultaneous 2D and 3D cell culture array for multicellular geometry, drug discovery and tumor microenvironment reconstruction. Biofabrication 2021, 13, 045013. [Google Scholar] [CrossRef]
- Lee, K.H.; Kim, T.H. Recent Advances in Multicellular Tumor Spheroid Generation for Drug Screening. Biosensors 2021, 11, 445. [Google Scholar] [CrossRef]
- Hong, S.; Rhee, S.; Jung, K.O. In vivo molecular and single cell imaging. BMB Rep. 2022, 55, 267–274. [Google Scholar] [CrossRef]
- Zhou, Q.; Xue, C.; Ke, X.; Zhou, J. Treatment Response and Prognosis Evaluation in High-Grade Glioma: An Imaging Review Based on MRI. J. Magn. Reson. Imaging 2022, 56, 325–340. [Google Scholar] [CrossRef] [PubMed]
- Sato, N.; Choyke, P.L. Whole-Body Imaging to Assess Cell-Based Immunotherapy: Preclinical Studies with an Update on Clinical Translation. Mol. Imaging Biol. 2022, 24, 235–248. [Google Scholar] [CrossRef] [PubMed]
- Bandula, S.; Magdeldin, T.; Stevens, N.; Yeung, J.; Moon, J.C.; Taylor, S.A.; Cheema, U.; Punwani, S. Initial validation of equilibrium contrast imaging for extracellular volume quantification using a three-dimensional engineered tissue model. J. Magn. Reson. Imaging 2016, 43, 1224–1229. [Google Scholar] [CrossRef] [PubMed]
- Yan, Y.; Sart, S.; Calixto Bejarano, F.; Muroski, M.E.; Strouse, G.F.; Grant, S.C.; Li, Y. Cryopreservation of embryonic stem cell-derived multicellular neural aggregates labeled with micron-sized particles of iron oxide for magnetic resonance imaging. Biotechnol. Prog. 2015, 31, 510–521. [Google Scholar] [CrossRef] [PubMed]
- Shen, F.H.; Werner, B.C.; Liang, H.; Shang, H.; Yang, N.; Li, X.; Shimer, A.L.; Balian, G.; Katz, A.J. Implications of adipose-derived stromal cells in a 3D culture system for osteogenic differentiation: An in vitro and in vivo investigation. Spine J. 2013, 13, 32–43. [Google Scholar] [CrossRef]
- Dhamecha, D.; Le, D.; Chakravarty, T.; Perera, K.; Dutta, A.; Menon, J.U. Fabrication of PNIPAm-based thermoresponsive hydrogel microwell arrays for tumor spheroid formation. Mater. Sci. Eng. C Mater. Biol. Appl. 2021, 125, 112100. [Google Scholar] [CrossRef]
- Hwang, Y.; Teoh, J.Y.; Kim, S.H.; Kim, J.; Jeon, S.; Kim, H.C.; Jung, Y.S.; Kim, H.; Choi, J.W.; Yoo, D. Simple Host-Guest Assembly for High-Resolution Magnetic Resonance Imaging of Microvasculature. ACS Appl. Mater. Interfaces 2021, 13, 27945–27954. [Google Scholar] [CrossRef]
- Bartusik, D.; Tomanek, B.; Lattová, E.; Perreault, H.; Fallone, G. Combined treatment of human MCF-7 breast carcinoma with antibody, cationic lipid and hyaluronic acid using ex vivo assays. J. Pharm. Biomed. Anal. 2010, 51, 192–201. [Google Scholar] [CrossRef]
- Casey, J.; Yue, X.; Nguyen, T.D.; Acun, A.; Zellmer, V.R.; Zhang, S.; Zorlutuna, P. 3D hydrogel-based microwell arrays as a tumor microenvironment model to study breast cancer growth. Biomed. Mater. 2017, 12, 025009. [Google Scholar] [CrossRef]
- Bartusik-Aebisher, D.; Bober, Z.; Zalejska-Fiolka, J.; Kawczyk-Krupka, A.; Aebisher, D. Multinuclear MRI in Drug Discovery. Molecules 2022, 27, 6493. [Google Scholar] [CrossRef]
- Marotta, M.; D’Armiento, F.P.; Martino, G.; Donato, G.; Nazzaro, A.; Vecchione, R.; Rosati, P. Glycosaminoglycans in human breast cancer: Morphological and biochemical study. Appl. Pathol. 1985, 3, 164–169. [Google Scholar]
- Truszkiewicz, A.; Aebisher DBartusik-Aebisher, D. Wybrane aspekty mające istotny wpływ na dokładność określania czasu relaksacji podłużnej T1 w systemie MR. Inżynier Fiz. Med. 2021, 10, 405–409. [Google Scholar]
- Orlińska, K.; Komosińska-Vassev, K.; Olczyk, K.; Kowalczyk, A.; Olczyk, P. Glycosaminoglycans—Types, structure, functions, and the role in wound healing processes. Ann. Acad. Medicae Silesiensis 2023, 77, 204–216. [Google Scholar] [CrossRef]
- Bashir, A.; Gray, M.L.; Boutin, R.D.; Burstein, D. Glycosaminoglycan in articular cartilage: In vivo assessment with delayed Gd(DTPA)(2-)-enhanced MR imaging. Radiology 1997, 205, 551–558. [Google Scholar] [CrossRef]
- Bashir, A.; Gray, M.L.; Hartke, J.; Burstein, D. Nondestructive imaging of human cartilage glycosaminoglycan concentration by MRI. Magn. Reson. Med. 1999, 41, 857–865. [Google Scholar] [CrossRef]
- Maroudas, A. Physicochemical properties of articular cartilage. In Adult Articular Cartilage, 2nd ed.; Freeman, M.A.R., Ed.; Pitman Medical: Kent, UK, 1979; pp. 215–290. [Google Scholar]
- Wedig, M.; Bae, W.; Temple, M.; Sah, R.; Gray, M. [GAG] profiles in “normal” human articular cartilage. In Proceedings of the 51st Annual Meeting of the Orthopaedic Research Society, Washington, DC, USA, 20–23 February 2005; p. 0358. [Google Scholar]
- Zheng, S.K.; Xia, Y. The impact of the relaxivity definition on the quantitative measurement of glycosaminoglycans in cartilage by the MRI dGEMRIC method. Magn. Reson. Med. 2010, 63, 25–32. [Google Scholar] [CrossRef]
- Rohrer, M.; Bauer, H.; Mintorovitch, J.; Requardt, M.; Weinmann, H.J. Comparison of magnetic properties of MRI contrast media solutions a different magnetic field strengths. Investig. Radiol. 2005, 40, 715–724. [Google Scholar] [CrossRef]
- Li, X.; Tian, S.; Ma, C.; Chen, L.; Qin, J.; Wang, N.; Lin, L.; Liu, A. Multimodal MRI for Estimating Her-2 Gene Expression in Endometrial Cancer. Bioengineering 2023, 10, 1399. [Google Scholar] [CrossRef]
- Chow, K.; Flewitt, J.A.; Green, J.D.; Pagano, J.J.; Friedrich, M.G.; Thompson, R.B. Saturation recovery single-shot acquisition (SASHA) for myocardial T(1) mapping. Magn. Reson. Med. 2014, 71, 2082–2095. [Google Scholar] [CrossRef]
- Ferreira da Silva, T.; Galan-Arriola, C.; Montesinos, P.; López-Martín, G.J.; Desco, M.; Fuster, V.; Ibáñez, B.; Sanchez-Gonzalez, J. Single breath-hold saturation recovery 3D cardiac T1 mapping via compressed SENSE at 3T. Magn. Reson. Mater. Phys. Biol. Med. 2020, 33, 865–876. [Google Scholar] [CrossRef] [PubMed]
- Nordio, G.; Bustin, A.; Odille, F.; Schneider, T.; Henningsson, M.; Prieto, C.; Botnar, R.M. Faster 3D saturation-recovery based myocardial T1 mapping using a reduced number of saturation points and denoising. PLoS ONE 2020, 15, e0221071. [Google Scholar] [CrossRef] [PubMed]
- Nordio, G.; Henningsson, M.; Chiribiri, A.; Villa, A.D.M.; Schneider, T.; Botnar, R.M. 3D myocardial T1 mapping using saturation recovery. J. Magn. Reson. Imaging 2017, 46, 218–227. [Google Scholar] [CrossRef] [PubMed]
- Wang, X.; Zhu, X.H.; Zhang, Y.; Divani, A.A.; Murphy, A.J.; Chen, W. A comparison study between the saturation-recovery-T1 and CASL MRI methods for quantitative CBF imaging. Magn. Reson. Imaging 2017, 37, 179–186. [Google Scholar] [CrossRef]
- Ladopoulos, T.; Matusche, B.; Bellenberg, B.; Heuser, F.; Gold, R.; Lukas, C.; Schneider, R. Relaxometry and brain myelin quantification with synthetic MRI in MS subtypes and their associations with spinal cord atrophy. Neuroimage Clin. 2022, 36, 103166. [Google Scholar] [CrossRef]
- Goto, M.; Hagiwara, A.; Kato, A.; Fujita, S.; Hori, M.; Kamagata, K.; Sugano, H.; Arai, H.; Aoki, S.; Abe, O.; et al. Estimation of intracranial volume: A comparative study between synthetic MRI and FSL-brain extraction tool (BET)2. J. Clin. Neurosci. 2020, 79, 178–182. [Google Scholar] [CrossRef]
- Truszkiewicz, A.; Bartusik-Aebisher, D.; Wojtas, Ł.; Cieślar, G.; Kawczyk-Krupka, A.; Aebisher, D. Neural Network in the Analysis of the MR Signal as an Image Segmentation Tool for the Determination of T1 and T2 Relaxation Times with Application to Cancer Cell Culture. Int. J. Mol. Sci. 2023, 24, 1554. [Google Scholar] [CrossRef]
- Truszkiewicz, A.; Aebisher, D.; Żyła, G.; Sobczak, J.; Wojtas, Ł.; Bartusik-Aebisher, D. Wpływ lepkości na pomiar czasu relaksacji podłużnej w diagnostyce z wykorzystaniem MR—Badania wstępne. Inżynier Fiz. Med. 2021, 10, 475–479. [Google Scholar]
- Smith, T.A. Towards detecting the HER-2 receptor and metabolic changes induced by HER-2-targeted therapies using medical imaging. Br. J. Radiol. 2010, 83, 638–644. [Google Scholar] [CrossRef] [PubMed]
- Wang, S.; Saboorian, M.H.; Frenkel, E.; Hynan, L.; Gokaslan, S.T.; Ashfaq, R. Laboratory assessment of the status of Her-2/neu protein and oncogene in breast cancer specimens: Comparison of immunohistochemistry assay with fluorescence in situ hybridisation assays. J. Clin. Pathol. 2000, 53, 374–381. [Google Scholar] [CrossRef] [PubMed]
- Lesperance, L.M.; Gray, M.L.; Burstein, D. Determination of fixed charge density in cartilage using nuclear magnetic resonance. J. Orthop. Res. 1992, 10, 1–13. [Google Scholar] [CrossRef] [PubMed]

| Cells | Week | No. of Bioreactors | Cells ± SD |
|---|---|---|---|
| MCF-7 | 1 | n = 6 | 533 × 104 ± 100 |
| 2 | n = 6 | 734 × 104 ± 020 | |
| 3 | n = 6 | 1451 × 104 ± 060 | |
| 4 | n = 6 | 4223 × 104 ± 190 | |
| 5 | n = 6 | 11,622 × 104 ± 140 | |
| 6 | n = 6 | 63,411 × 104 ± 210 |
| Cell Line | Week | MR Relaxation Time | |
|---|---|---|---|
| MEN ± SD T1 [ms] | MEN ± SD T2 [ms] | ||
| MCF7 | 1 | 1100 ± 40 | 171 ± 10 |
| 2 | 1060 ± 56 | 168 ± 31 | |
| 3 | 911 ± 23 | 155 ± 33 | |
| 4 | 856 ± 11 | 149 ± 19 | |
| 5 | 795 ± 31 | 137 ± 21 | |
| 6 | 673 ± 59 | 128 ± 12 | |
| Week | GAG (mg/mL) |
|---|---|
| 1 | 1.045 |
| 2 | 1.25 |
| 3 | 1.89 |
| 4 | 1.95 |
| 5 | 2.17 |
| 6 | 2.29 |
Disclaimer/Publisher’s Note: The statements, opinions and data contained in all publications are solely those of the individual author(s) and contributor(s) and not of MDPI and/or the editor(s). MDPI and/or the editor(s) disclaim responsibility for any injury to people or property resulting from any ideas, methods, instructions or products referred to in the content. |
© 2024 by the authors. Licensee MDPI, Basel, Switzerland. This article is an open access article distributed under the terms and conditions of the Creative Commons Attribution (CC BY) license (https://creativecommons.org/licenses/by/4.0/).
Share and Cite
Guz, W.; Podgórski, R.; Aebisher, D.; Truszkiewicz, A.; Machorowska-Pieniążek, A.; Cieślar, G.; Kawczyk-Krupka, A.; Bartusik-Aebisher, D. Utility of 1.5 Tesla MRI Scanner in the Management of Small Sample Sizes Driven from 3D Breast Cell Culture. Int. J. Mol. Sci. 2024, 25, 3009. https://doi.org/10.3390/ijms25053009
Guz W, Podgórski R, Aebisher D, Truszkiewicz A, Machorowska-Pieniążek A, Cieślar G, Kawczyk-Krupka A, Bartusik-Aebisher D. Utility of 1.5 Tesla MRI Scanner in the Management of Small Sample Sizes Driven from 3D Breast Cell Culture. International Journal of Molecular Sciences. 2024; 25(5):3009. https://doi.org/10.3390/ijms25053009
Chicago/Turabian StyleGuz, Wiesław, Rafał Podgórski, David Aebisher, Adrian Truszkiewicz, Agnieszka Machorowska-Pieniążek, Grzegorz Cieślar, Aleksandra Kawczyk-Krupka, and Dorota Bartusik-Aebisher. 2024. "Utility of 1.5 Tesla MRI Scanner in the Management of Small Sample Sizes Driven from 3D Breast Cell Culture" International Journal of Molecular Sciences 25, no. 5: 3009. https://doi.org/10.3390/ijms25053009
APA StyleGuz, W., Podgórski, R., Aebisher, D., Truszkiewicz, A., Machorowska-Pieniążek, A., Cieślar, G., Kawczyk-Krupka, A., & Bartusik-Aebisher, D. (2024). Utility of 1.5 Tesla MRI Scanner in the Management of Small Sample Sizes Driven from 3D Breast Cell Culture. International Journal of Molecular Sciences, 25(5), 3009. https://doi.org/10.3390/ijms25053009

